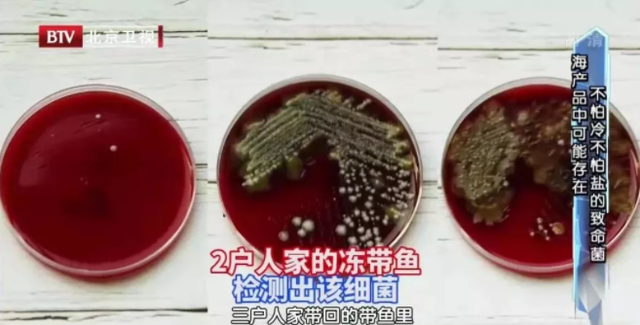
dha是补钙的吗（补钙是打钙针好还是骨肽好）-硒宝网

dha是补钙的吗(补钙是打钙针好还是骨肽好)
小时候总听大人们说“多吃鱼好,吃鱼会变聪明”,这话其实不假,特别是海鱼,其中富含的一些营养素对健脑益智尤为重要。
然而说起海鱼,很多人的第一印象就是三文鱼,它不仅价格比较高昂,不少国人还吃不惯。其实,另外有一种鱼,营养可以和三文鱼相媲美,价格还便宜得多,关键是吃法多样,更适合中国人的“胃”。这种海鱼就是带鱼。
这种“高性价比”的海鱼
你可别错过
带鱼是我国沿海产量最高的经济鱼类之一,其中以白带鱼最为常见。白带鱼鱼体呈银白色,背面呈暗灰色,主要以小型鱼虾为食,肉质鲜美味道佳,营养也很是丰富。
1高蛋白
带鱼的蛋白质含量较高,每百克含量约为17.7克,相当于吃了两个半的鸡蛋或70克的鸡胸肉,对于需要补充蛋白质、增肌强体的人群来说是不错的选择。

2高DHA、EPA
带鱼的脂肪虽然比一般鱼类含量略高些,但其中多为不饱和脂肪酸,尤其是DHA和EPA这两种物质含量更是丰富。据统计,带鱼的DHA含量是三文鱼的2倍多,EPA含量是三文鱼的3倍左右。
EPA是一种人体无法合成、必须从食物获取的物质,它可促进体内饱和脂肪酸的代谢,适当补充能帮助降低心血管事件的发生风险;DHA俗称“脑黄金”,它可促进脑细胞的生长发育,改善大脑机能,提高记忆力。
3钙量丰富
在常见的动物性食物中,带鱼的含钙量位居第二位,远高于鸡鸭以及猪牛羊等常见肉类。而且带鱼中还富含两种补钙的“黄金搭档”——维生素D和镁,它们能促进身体对钙的吸收利用,协同帮助降低骨质疏松的发生风险。

4丰富维生素
除了维生素D之外,带鱼中还含有维生素A、维生素E、维生素B2、维生素B6、维生素B12、烟酸、泛酸等多种维生素,含量也不算低,比如每百克带鱼的维生素B2含量可满足一日推荐摄入量的50%左右。此外,带鱼中的钾、磷、锌等矿物质含量也比较丰富。
从挑选到保存,处处有窍门
带鱼主要生活在20~40米深的海底,生存环境气压比较高,打捞起来后存活时间一般不超过3小时,很容易死亡。为了防止变质,多采用冷冻方式,所以我们平时在市场里看到的带鱼都是冷冻的。
那如何从中挑选出新鲜、品质佳的?家中保存时我们又该注意什么呢?
1按按这里判别新鲜度
大家在购买带鱼的时候,可以用手指轻按带鱼的腹部,如果按起来非常有弹性,那就说明带鱼很新鲜;如果按起来十分松软、不会回弹,那可能已经存放很久了。
大家还可以观察一下鱼眼睛。鱼眼黑白分明、看起来明亮的较为新鲜,鱼眼暗淡无光的则不建议选购。另外,带鱼外表银色鱼鳞分布均匀、完整的比较新鲜,剐蹭较多、银色看起来不均匀的可能也不太新鲜。

2冷冻保存有讲究
根据膳食指南的推荐,普通成人每天宜食用水产45~75g,也就是2~3块带鱼的量。买回家中一次吃不完的带鱼,建议冷冻保存。
冷冻带鱼时,建议大家先清洗干净,然后将其分成每餐吃的量,一份份分装好,再装入食品袋中,尽量排出空气后封口,可以冷冻保存3~4个月。

除了不能反复解冻、小心交叉感染之外,还有一点大家也要注意——买回来的海产品中可能存在有副溶血性弧菌。
这是一种海洋细菌,它可以通过消化道、血液等感染人体,造成腹痛、腹泻、呕吐等症状,甚至可能引发溶血、致死。之前大医生节目曾对三户人家走访,在其中2户人家的冷冻带鱼中都发现了这种细菌。
副溶血性弧菌不怕冷、不怕盐,但很怕酸,所以大家在烹饪前可以用白醋再处理一下带鱼,然后再高温彻底加热。这样既能帮助杀菌,又有助于去除腥味。
带鱼的推荐吃法
很多人喜欢干炸带鱼,烹香开胃,很是解馋。但是,油炸的烹饪方式一是会带来过多的脂肪和热量,二是会破坏带鱼中的不饱和脂肪酸,甚至可能产生有害物质,所以并不推荐大家这样吃。相比来说,红烧、清蒸等做法更适合。
红烧带鱼
做法:带鱼处理干净后用葱、姜、料酒腌制一下,吸干水分,蘸上蛋液,放入锅中煎至成形,盛出备用。锅内倒油,下入葱姜蒜、花椒、大料炒香,加入白醋、白糖、料酒、生抽、老抽、清水,放入带鱼和香菜根,用中火烧至成熟入味后即可出锅。

老北京蒸带鱼
做法:带鱼剔骨改花刀,切成鱼片后用盐、蛋清、生粉进行腌制,然后鱼皮朝上,放上姜丝卷起放入盘中。雪里蕻提前焯水切碎,铺在带鱼卷上,干黄花菜提前浸泡切碎,和浸泡的汤水一起淋在带鱼卷上。将带鱼放入蒸锅,上汽蒸5分钟即可。
注意:带鱼虽好,但它的嘌呤含量比较高,尤其是它表面的银膜,嘌呤含量是鱼肉的7倍多,患有痛风及尿酸高的人群应慎食哦!

(我是大医生官微)
